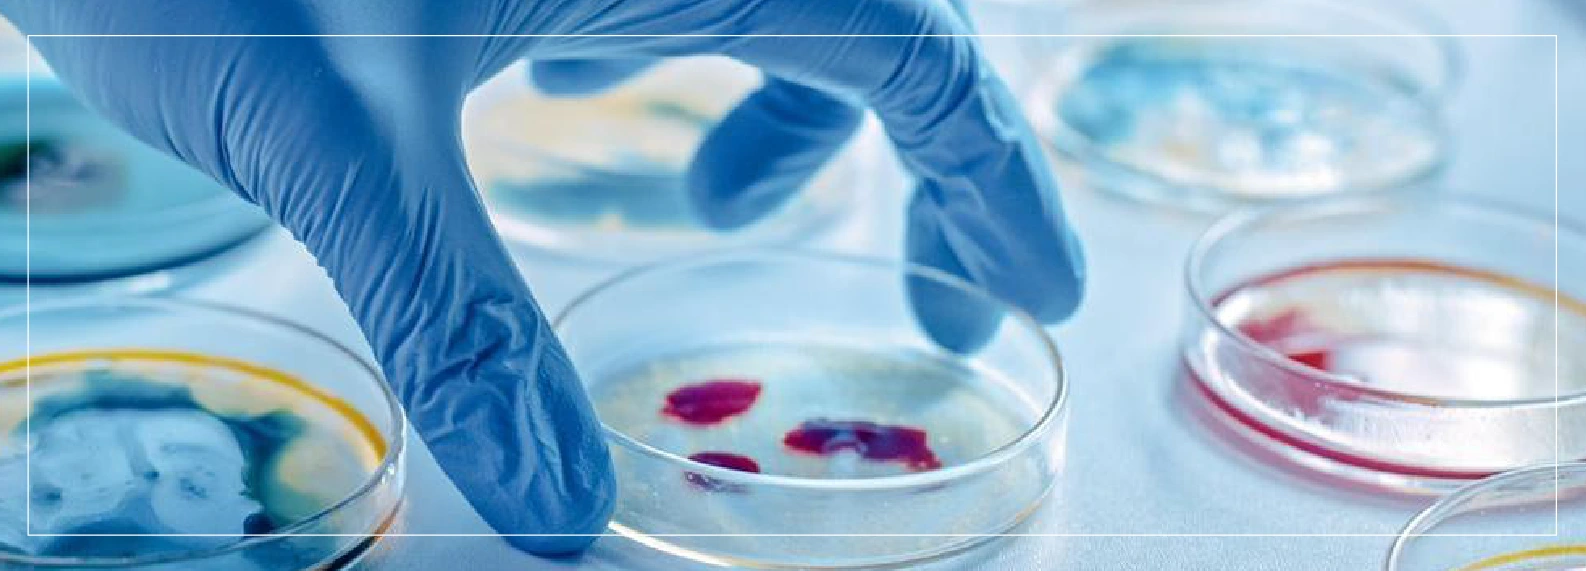
...

Лучшая Гель-Документирования Система для Лабораторий в Таджикистане

Лучшие Производители Лабораторного Оборудования в Иране

Лучшие ПЦР-аппараты для Лабораторий в Казахстане

Развитие Автоматизированных Лабораторий и Искусственный Интеллект в Биотехнологии

Лучшие Лабораторные Центрифуги для Клиник и НИИ в России

Использование вихревого смесителя в лаборатории: определение, применение, принцип работы, эксплуатационная процедура

Нужно ли Калибровать Мое Лабораторное Оборудование? И Как Это Сделать?
Как Чистить и Обслуживать Аппарат для Гель-Электрофореза?

8 Признаков того, что Пора Обновить Устаревшее Лабораторное Оборудование

Как Работает Горизонтальный Гель-Электрофорез?



















